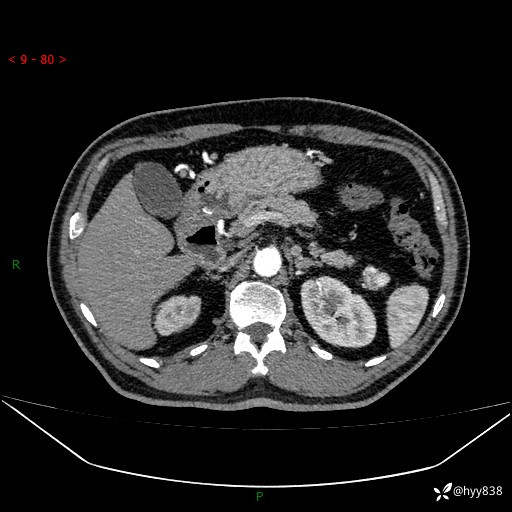
img

偶然发现胰腺尾部占位,富血管强化且持续强化,看看你的疾病谱---(有结果)
患者性别:男
患者年龄:57岁
主诉:发现胰腺体尾部占位5天
简要病史:患者于5天前因肾积水在当地医院行检查发现胰体尾一明显占位性改变,考虑胰腺肿瘤可能,无剑突下及右上腹疼痛不适,无明显反酸、嗳气,无畏寒、头晕、头痛,无尿频、尿急、尿痛等不适,今为求进一步治疗特来我院就诊,门诊以“胰腺肿物”收住我科。 患者病程中精神、睡眠、饮食尚可,大小便正常、体力体重无明显变化
体格检查:(-)
辅助检查:CT
临床诊断:胰腺肿物
治疗经过:手术
讨论:病变性质?
胰腺CT平扫









增强动脉期

静脉期







最后编辑于 2023-11-12 · 浏览 2271